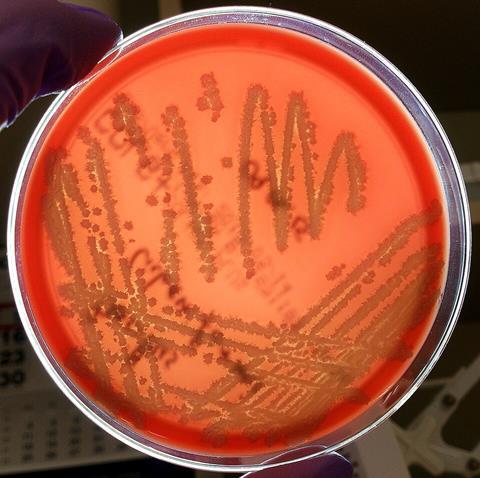

Promoters are crucial expression elements in synthetic biology, and Bacillus licheniformis serves as an excellent chassis cell for industrial production. However, compared with constitutive and carbon source-inducible promoters, nitrogen source-responsive promoters are lacking, restricting the application of B. licheniformis expression systems.
This study initially predicted nitrogen-responsive promoter elements through genomic analysis. Using enhanced green fluorescent protein (egfp) as a reporter gene, transcriptional initiation characteristics were evaluated.
Researchers found PglnR and Pgcv promoters could initiate transcription in response to sodium glutamate, with transcriptional intensities 200% and 100% higher than the control group at 36 h. Subsequently, these screened promoters were employed to mediate the expression of transglutaminase gene. In fed-batch fermentation using a 5-L glass fermentor, the recombinant strain achieved peak enzyme activity of 14.7 U/mL.
The work entitled “Mining, identification, and application of nitrogen-responsive promoters in Bacillus licheniformis” was published on Systems Microbiology and Biomanufacturing (published on September 03, 2025).

No comments yet